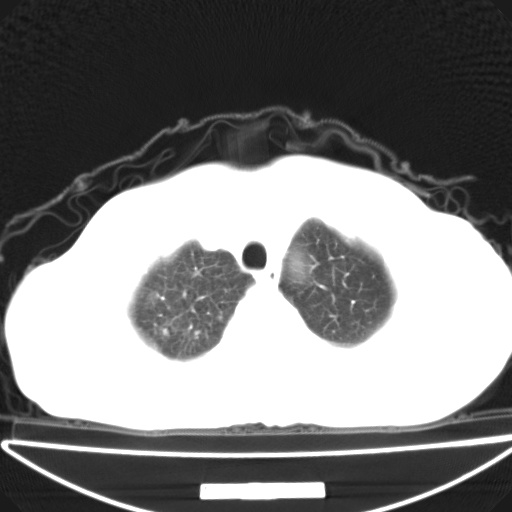
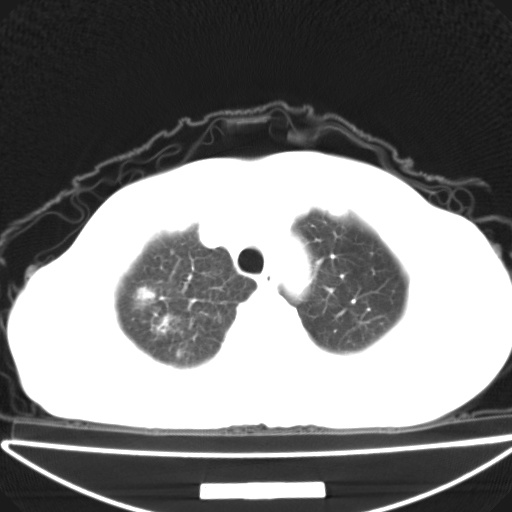
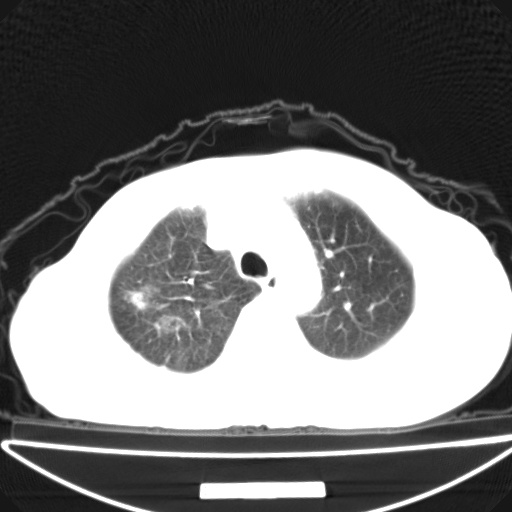
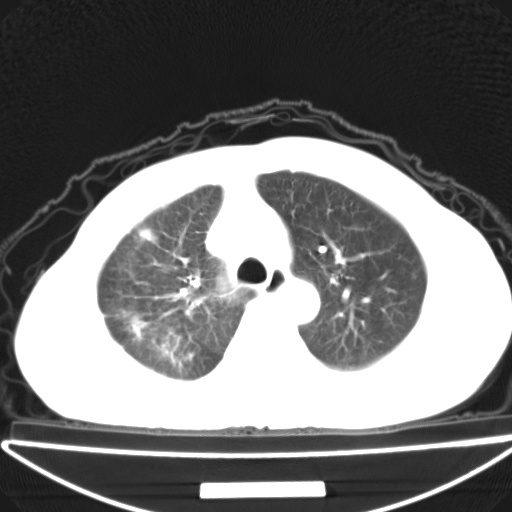
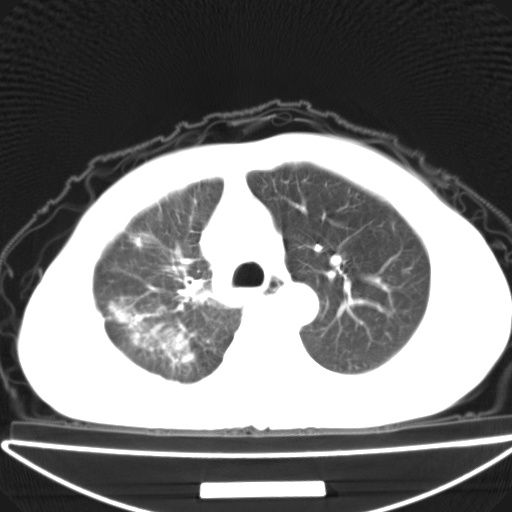
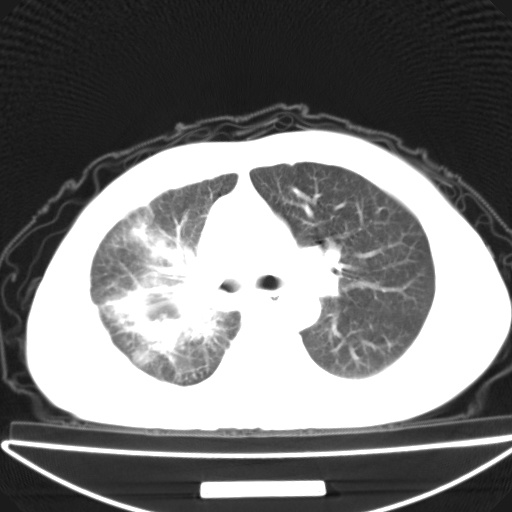
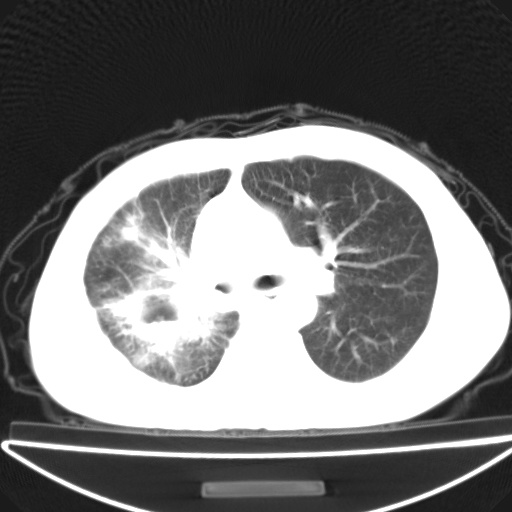

以下是引用zsl6918在2008-11-6 19:28:00的发言:[br]图象资料太少了,继续上传吧
以下是引用jsgdoctor在2008-11-6 22:12:00的发言:[br]右主支气管壁明显增厚,管腔狭窄.考虑为右侧中央型肺癌伴阻塞性炎症\\肺脓肿.
以下是引用zjzjr在2008-11-6 20:25:00的发言:[br]中心型肺ca,合并阻塞性肺炎
以下是引用zsl6918在2008-11-6 19:43:00的发言:[br]右侧中心性肺癌(鳞癌)
| 欢迎光临 医影在线 (http://bbs.radida.com/bbs/) | Powered by Discuz! X3.2 |